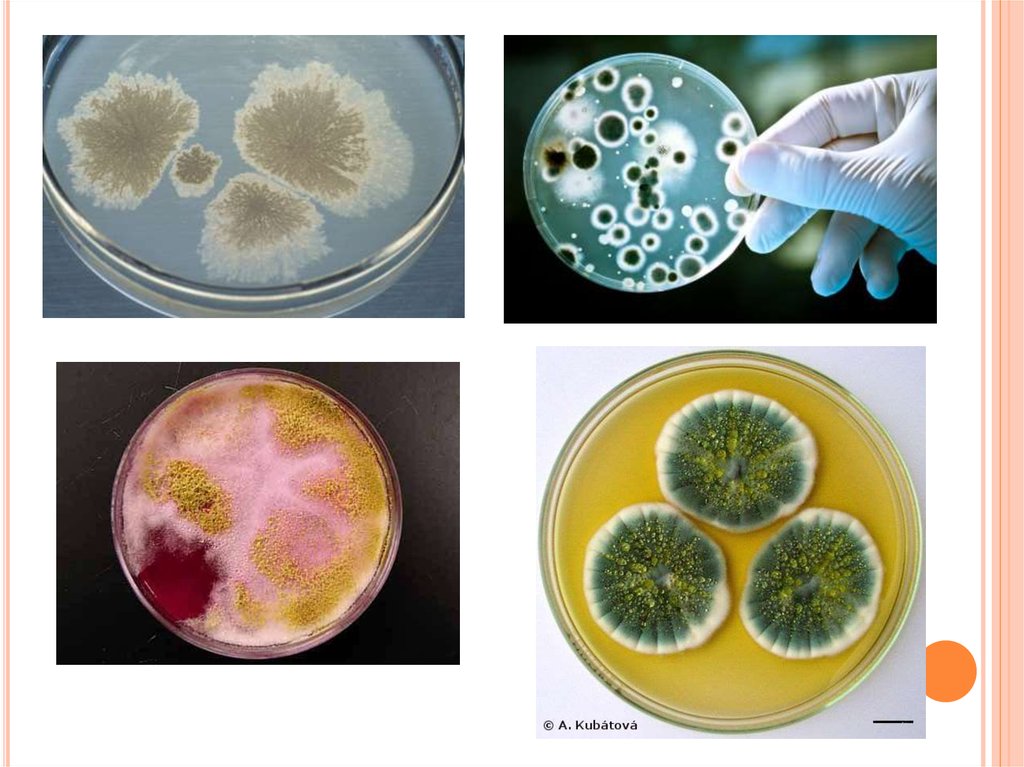

Modern science is moving further away from a one-size-fits-all approach to treatment. Personalized medicine is now the main focus for researchers. This means that the approach to each person is becoming truly unique, and modern technologies are making this possible. Biological markers act as precise indicators: they reveal hidden aspects of the body, predict risks, and help find the perfect therapy. Such discoveries are happening right before our eyes, affecting completely different areas from treating complex diseases to unlocking the reserves of the human brain.
Fighting infections and biomarker-based tests for assessing vulnerability
One of the most unexpected areas of growth has been the study of pathogenic fungi. Until recently, doctors fought them using standard protocols, but now the rules of the game have changed. Scientists are actively developing biomarker-based tests to understand the level of danger before a person comes face to face with the disease. It turns out that vulnerability to fungal infections depends heavily on our genetic makeup and the current state of our immune system.
Special blood tests check for specific proteins, molecules, and mutations. This screening gives doctors crucial information: who will need extra protection and prevention, and whose body can fight off the threat on its own. This approach is especially important for people with weakened immune systems, for whom a timely risk assessment becomes the main key to a long and healthy life.
Lion’s mane mushroom for improving memory and restoring nerve cells
Interestingly, the fungal kingdom brings us not only new reasons for concern, but also amazing tools for healing. While some laboratories are looking for protection against harmful strains, another fungus is causing a real revolution in neurobiology. We are talking about the Lion’s mane mushroom. For a long time, this fluffy fungus remained a top supplement for biohackers looking to boost concentration and productivity. However, recent scientific studies have moved it from a trendy fad to a highly promising therapeutic agent.
Researchers have extracted active compounds from Lion’s mane that can directly affect how our brain works. Laboratory tests have shown a striking result: under the influence of these substances, neuron branches actively grow and form new connections. Brain cells seem to wake up, expanding their growth cones. These microscopic structures help neurons “feel” their way through space and quickly connect with their neighbors. This exact process is the foundation of our ability to remember new information and adapt to changes. Scientists now hope that Lion’s mane extract will become a starting point for creating powerful drugs against age-related cognitive decline.
It paints quite an amusing picture: with some fungi we learn to fight effectively using high technology, while we take others as allies to develop our intellect. These breakthroughs clearly show the direction modern science is taking. Doctors are no longer fighting diseases blindly. They are fine-tuning their methods, carefully reading our body’s signals through biomarkers, and finding elegant solutions in the most unexpected places.